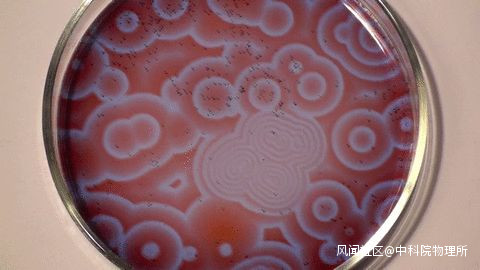

“咔嚓”咬一口寶塔菜,背後分形的秘密竟然是..._風聞
中科院物理所-中科院物理所官方账号-2022-03-20 14:10
原創:中科院物理所
隨着天氣轉暖,小編也把厚厚的棉衣收了起來,換上了輕便的春裝。然而…沒有了厚衣服的遮擋,過年不慎補充的全身脂肪覆蓋層變得尤為突出…

為了以全新的面貌迎接春天,小編也開始了“全身脂肪覆蓋層無痛消除術”,然而在跑步機上跑着跑着,想到了中午為了減肥才吃的寶塔菜,忽然感覺自己陷入了一個巨大的謎團,怎麼這種蔬菜的形狀越想越奇怪???

經過一番縝密的思考,小編認為努力思考同樣可以達到“全身脂肪覆蓋層無痛消除術”的目的,進而將每日份的運動替換為每日份思考寶塔菜…沒想到,小小的寶塔菜背後的故事這麼引人入勝…

可預測性
在我們從小到大學習知識的數理課堂中,我們逐漸感受到世界是充滿秩序的:已知表達式和定義域的函數,其曲線走向是可預測的;已知化學反應的反應物與反應條件,生成物是可預測的;已知運動物體的初始位置與運動規律,接下來任意時刻的速度與位置是可預測的…
我們對科學帶來的這種“可預測性”的印象,一部分源於伽利略(Galileo Galilei)和牛頓(Issac Newton)對鐘擺擺動的研究。
1581年,伽利略觀察吊燈的擺動時,意識到了擺動這個現象存在着可被預測的規律。經過一段時間的觀察,伽利略發現儘管擺動幅度不同,但晃動吊燈來回擺動一次的時間是一樣的。

圖片來源:pixabay
為了對這個有趣的現象進行進一步的探究,伽利略用大小不同、長度相同的鐘擺進行擺動週期實驗,他用自己的脈搏來計時。
**最終證實了鐘擺的擺動時間不取決於器大小,也不取決於其位置,只取決於其長度。**在伽利略的這項研究開始,鐘擺的擺動變得可預測了。
在伽利略之後,牛頓利用微分方程得到了鐘擺的長度(l)與擺動週期(T)之間的精確數學關係:

這使得我們在“可預測性”上有了更大的進展,鐘擺擺動的運動規律不僅可以被定性的預測,還可以被精確地定量預測。
我們知道,牛頓發現了許多現象背後的定律,並且發明了微積分等數學方法作為有力的工具幫助我們理解宇宙的基本定律。
其中,我們最為熟悉的牛頓三大定律簡潔優美的描述了宏觀物體的運動規律。也讓我們認識到,將運動現象背後的規律用數學公式來描述,特別是微分方程,可以精確地描述運動如何隨時間演化,也就是可預測性。
可預測性無疑是讓人着迷的,但仔細想想,是否所有的現象都可以用這種以“可預測性”為基礎的科學思想來描述呢?
混沌(Chaos)
從“是否可被預測”出發,我們可以想到很多非常貼近日常生活的例子:長期天氣預報、動物種羣數量的發展,等等。這些例子中似乎隱藏着更加迷人的“不可預測性”。
我們無法通過微分方程精確的獲得大氣運動的信息,這些例子比起“鐘擺擺動”這樣的例子有什麼不同呢?
想到“不確定性”,我們可能會對其概念感到陌生和模糊,從科學研究的角度出發,不確定性被定義為**“系統前後不同時刻間存在的某種隨機關係,而從統計學意義上來講,主要表現為當下與未來之間的因果關係”**。
“不確定性”吸引着研究者們,逐漸發展出了一門新興的學科——混沌(Chaos)。
在19世紀80年代末,從Henri Poincaré對天體力學中的三體問題的研究開始,混沌就開始出現在了科學研究領域。

Edward Lorenz | 圖片來源 [3]
直到1963年,麻省理工學院的一位氣象學家Lorenz的研究認為對於確定性的可預見性是一種錯覺,並由此產生了一個仍然蓬勃發展的領域——混沌理論。
混沌理論認為哪怕是最簡單的方程式(不含任何隨機因子),一切可知,只要運行過程中出現一點點偏差,結果也會跟最初的設想大相徑庭。
蝴蝶效應——敏感依賴性
在當時,預測天氣有兩種方式:第一,使用線性程序預測天氣,其前提是明天的天氣是今天天氣特徵的一個定義良好的線性組合;第二,通過模擬大氣流動的流體動力學方程來更準確地預測天氣。
在一次對比這兩種計算方式時,Lorenz發現計算機模擬得出兩個月以後的天氣數據與以往的大不相同。然而Lorenz發現這次計算的“錯誤”竟然源自模擬過程中初值的四捨五入。
由此,Lorenz發現了混沌的一個定義性質——對初值的敏感依賴性。下圖中的這裏球體代表洛倫茲方程的迭代。

洛倫茨吸引子 | 圖片來源 [3]
1972年,在一次會議中,Lorenz講述了一個題為“可預測性:巴西蝴蝶扇動翅膀會在德克薩斯州引發龍捲風嗎?”的報告。
他用一隻蝴蝶來比喻一個微小的、看似無關緊要的、可以改變天氣進程的微擾——也就是我們所熟知的“蝴蝶效應”。

圖片來源:pixabay
讀到這裏,你可能會自然而然的產生的一個疑問:計算機模擬通常會在某一時刻引入舍入誤差,而這個誤差會被混沌所放大,那麼Lorenz的解可以反應真實的混沌軌跡嗎?
答案是肯定的,這是因為一種被稱為“陰影”(Shadowing)的特性:儘管對於任何給定的初始條件,數值軌跡都與精確的軌跡不同,但在附近總存在一個初始條件,它的精確軌跡在預先規定的一段時間內被數值軌跡近似。
混沌吸引子(Chaotic Attractor)
通過對混沌系統的研究,Lorenz在1963年正式提出了洛倫茲方程,其典型的軌跡往往會收斂到一個非整數的有界結構,如上圖所示,被稱為混沌吸引子(Chaotic Attractor)。
混沌吸引子的引入可以方便我們理解,混沌系統由於對初值具有敏感依賴性,其軌跡何時會發生“混亂”。
首先,位於吸引子上的軌跡會表現出不同於線性系統的混沌行為,除此之外,任何位於吸引子吸引域內的點同樣會產生向吸引子收斂的混沌軌跡。
由於混沌吸引子的存在,不同於單擺軌跡存在週期性,混沌系統中則是不存在週期性軌跡的,或者可以説——週期性軌跡是發散的。
這也是混沌的本質特徵:非週期性意味着敏感依賴,敏感依賴是非週期性的根本原因。
分形(Fractal)
是不是從上面的概念走出來已經有點雲裏霧裏了?沒關係,寶塔菜這不就要來了嗎!

提到混沌,總是離不開另一個概念——分形。比起前面提到的抽象概念,分形更加具象化,在日常生活中也有很多例子。

寶塔菜形貌 | 圖片來源:pixabay

樹枝的分形 | 圖片來源:pixabay

曼德勃羅集 | 圖片來源:pixabay
通過以上三幅圖片我們可以看出,分形似乎是指從小尺度到大尺度圖形的相似性,那麼,分形的準確的定義是什麼呢?
分形結構或分形過程可以粗略地定義為具有在尺度上保持恆定的特徵形式,即具有自相似的性質。
如果一個結構的小尺度形式與大尺度形式相似,那麼它就是分形的。
仔細想想,寶塔菜給我們奇怪的感覺似乎就來源於分形,它的形貌和我們通常接觸到的幾何圖形都不同。
從混沌到分形
在上文中,我們分別介紹了混沌與分形,這二者之間的關係又是什麼樣子的呢?
**混沌吸引子通常是分形的。**我們可以考慮混沌吸引子附近相空間中點的軌跡:受到混沌吸引子的影響,附近相空間中的點會表現出非線性的趨勢,即分別在不同的方向上受到混沌吸引子的拉伸和收縮。
在拉伸和收縮的共同作用下,相空間中的點會形成“細絲”,由於軌跡是有界的,這些“細絲”會自然而然的摺疊。
當混沌吸引子帶來的這種影響無限期的重複,產生的結果就是分形。
類似於我們通過圖像可以獲得相關的物理信息,混沌吸引子的幾何結構可以定量地與其動力學特性相關。
混沌、分形這些概念聽起來特變抽象,比起Lorenz研究的氣象系統,有沒有更加生動簡單的例子可以反映出混沌理論的思想呢?
生物學中的混沌
混沌理論竟然和生物學領域高度相關,用這種思想進行生物學研究的科學家同樣也讓小編感到意外——艾倫·麥席森·圖靈(Alan Mathison Turing)。
圖靈對胚胎髮育過程進行了深刻的思考,他認為可以用簡單的數學公式來描述這個複雜的過程。
最開始,胚胎內部的細胞是完全一樣的,會按照簡單規律進行自組織,自組織的過程不斷重複,直到某個階段開始會突然呈現複雜模式,逐漸形成各種不同的細胞,最終發育成不同的器官——這個過程被稱為形態發生。
圖靈嘗試用數學來解釋生命體如何從自然、均勻的狀態逐漸演變成不均勻的重複圖案,即從自組織到模式出現的過程。
另一方面,著名的別洛烏索夫(Belousov)振盪實驗也是自組織導致模式自發形成的例子。
他發現,**將兩種溶液混合形成有色液體,液體變得澄清,再變為有色…**一直循環往復這一過程。
別洛烏索夫振盪反應 | 圖片來源
別洛烏索夫溶液自發產生的隨機漣漪圖案狀説明:**系統在不受外部條件因素干擾的情況下可以自發無規律變化。**這同樣是由自組織到模式形成的例子。
寶塔菜的分形
學習了這麼多有關混沌、分形在數學領域和生物學領域的知識,我們依然要不忘初心——那為啥寶塔菜長分形了呢?
首先,我們需要了解植物的器官是怎麼發育而來的——在整個發育過程中,植物分生組織定期以螺旋、對生或輪生方式產生器官。
想想普通的花菜,其特殊的結構源於**每一個分生組織產生的初生花原基都沒有最終發育到開花階段,而是重複性的產生了更多相同的初生花原基,**類似於一個發育過程中的“雪崩”效應。

花菜 | 圖片來源:pixabay
而寶塔菜結構的自相似性是因為分生組織雖然最終不能形成花,但在發育過程中,初生花原基短暫的出現了一個“魂穿”的過程,即短暫的保持着花的“記憶”。
這一短暫的過程影響分生組織的生長,產生了額外的突變,可誘導產生圓錐形結構,最終形成了具有自相似特徵的圓錐結構,也就是分形。

寶塔菜的分形結構 | 圖片來源:pixabay
想不到尋常的寶塔菜背後竟然隱藏着這麼多複雜的知識點,果然是最高端的知識只需要最樸素的展現方式啊~
現在,無論是混沌還是分形,都逐漸與物理、數學、生物、化學等領域進行融合,交叉發展出了很多新奇有趣的成果,你還知道哪些相關的有趣現象呢?
參考文獻
[1] 陳璐. 一個具有自組織結構超混沌系統的控制與同步研究[D].東北師範大學,2019.
[2] 王翔. 分佈混沌理論及其應用研究[D].大連理工大學,2021.
[3] Physics T oday 66, 5, 27 (2013).
[4] The Secret Life of Chaos, BBC.
[5] Sean Bailly,L’art fractal du chou romanesco, Pour la Science, Septembre, 9, (10-11), (2021).